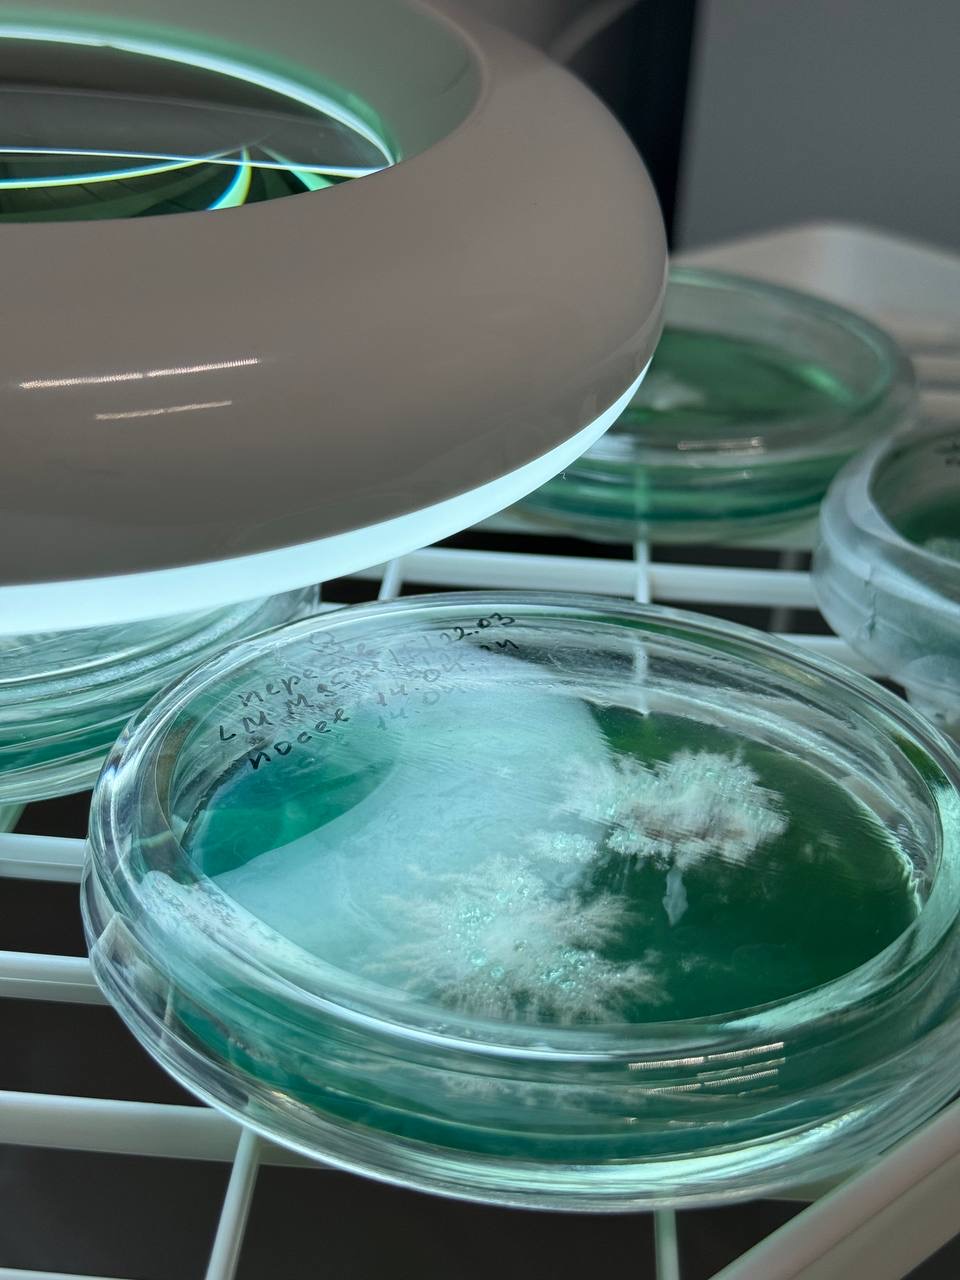

GribGrow "ГрибГроу" — российская ферма функциональных грибов полного цикла: от выращивания мицелия до производства готовых ингредиентов для здоровья, науки и бизнеса.
Мы специализируемся на культивировании ценных видов грибов: Ежовик гребенчатый (Hericium erinaceus), Кордицепс вооружённый (Cordyceps militaris), Рейши (Ganoderma lucidum) и Траметес разноцветный (Trametes versicolor).
Используем современные технологии выращивания и строгий контроль качества, чтобы гарантировать стабильность, чистоту и высокую биологическую активность продукции.
Мы специализируемся на культивировании ценных видов грибов: Ежовик гребенчатый (Hericium erinaceus), Кордицепс вооружённый (Cordyceps militaris), Рейши (Ganoderma lucidum) и Траметес разноцветный (Trametes versicolor).
Используем современные технологии выращивания и строгий контроль качества, чтобы гарантировать стабильность, чистоту и высокую биологическую активность продукции.
О нас
Наши преимущества
Собственное производство
Мы самостоятельно контролируем все этапы: подготовку субстрата, стерилизацию, инокуляцию, инкубацию и сбор продукции.
Это позволяет нам обеспечивать стабильное качество, чистоту мицелия и соответствие технологическим стандартам.
Это позволяет нам обеспечивать стабильное качество, чистоту мицелия и соответствие технологическим стандартам.
Профессиональное оборудование
Используем автоклавы промышленного класса, системы контроля температуры и влажности, а также лабораторные методы проверки чистоты.
Технологическая дисциплина и стандартизация процессов позволяют получать безопасный и стабильный продукт.

Технологическая дисциплина и стандартизация процессов позволяют получать безопасный и стабильный продукт.

Услуги для производителей
Предлагаем контрактное выращивание мицелия и грибной продукции под вашим брендом.
Работаем с производителями БАД, функционального питания, фармацевтическими и исследовательскими компаниями.
Работаем с производителями БАД, функционального питания, фармацевтическими и исследовательскими компаниями.
Собственное производство
На нашей ферме соблюдаются санитарные и технологические нормы выращивания грибов.
Производство включает несколько этапов контроля:
• подготовка и стерилизация субстрата
• внесение чистой культуры мицелия
• инкубация в контролируемой среде
• визуальный и лабораторный контроль качества
Мы минимизируем риск контаминации и обеспечиваем стабильную биомассу с высоким содержанием активных соединений.
Производство включает несколько этапов контроля:
• подготовка и стерилизация субстрата
• внесение чистой культуры мицелия
• инкубация в контролируемой среде
• визуальный и лабораторный контроль качества
Мы минимизируем риск контаминации и обеспечиваем стабильную биомассу с высоким содержанием активных соединений.
Профессиональное оборудование
GribGrow "ГрибГроу" инвестирует в промышленное стерилизационное оборудование, лабораторные инструменты и системы климат-контроля.
Использование автоклавов и контролируемых инкубационных камер обеспечивает:
✔ стерильность субстрата
✔ стабильность роста мицелия
✔ воспроизводимость результата
✔ высокую концентрацию биоактивных веществ
Это позволяет нам соответствовать требованиям производителей БАД и функционального питания.
Использование автоклавов и контролируемых инкубационных камер обеспечивает:
✔ стерильность субстрата
✔ стабильность роста мицелия
✔ воспроизводимость результата
✔ высокую концентрацию биоактивных веществ
Это позволяет нам соответствовать требованиям производителей БАД и функционального питания.
Услуги для наших клиентов
Мы работаем как с частными клиентами, так и с бизнесом.
Для частных клиентов:
продажа мицелия для выращивания
консультации по культивированию
поставка грибной продукции
Для бизнеса:
контрактное производство
разработка грибных ингредиентов
оптовые поставки
производство под СТМ
Наша задача — создать надёжную технологическую базу для партнёров и обеспечить стабильные поставки продукции.
Для частных клиентов:
продажа мицелия для выращивания
консультации по культивированию
поставка грибной продукции
Для бизнеса:
контрактное производство
разработка грибных ингредиентов
оптовые поставки
производство под СТМ
Наша задача — создать надёжную технологическую базу для партнёров и обеспечить стабильные поставки продукции.
Капсулирование в ТЖК размер капсул
#0 и #00
Фасовка и упаковка готовой продукции
Помощь в сертификация продуктов
Контрактное производство
СТМ (собственная тогровая марка) для маркетплейсов
Протокол исследований


«Наша миссия»
Мы развиваем культуру функциональных грибов в России, создавая качественные и научно обоснованные продукты на основе мицелия.
«Почему выбирают GribGrow - ГриГроу»
Прозрачность производства
Технологическая дисциплина
Работаем по всей России
Консультационная поддержка
Возможность контрактного производства
Технологическая дисциплина
Работаем по всей России
Консультационная поддержка
Возможность контрактного производства